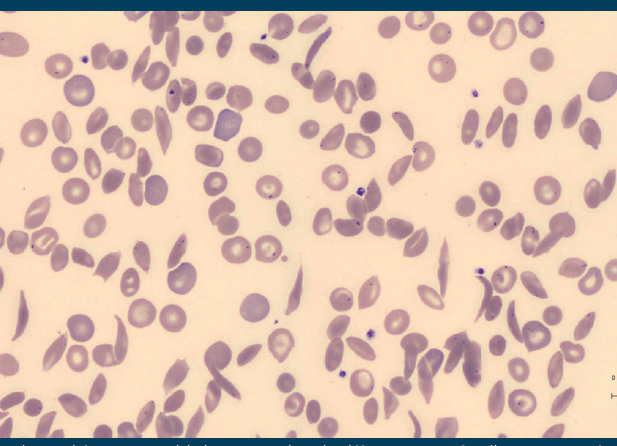
Auto uploaded image

Centre de la drépanocytose de la Citadelle
Le 19 juin, la Journée Mondiale de la Drépanocytose fut à nouveau l’occasion de mieux faire connaître cette maladie génétique parmi les plus fréquentes au monde. Au CHR Liège, toute une équipe, le « drépanogroupe » se mobilise pour permettre une prise en charge optimale du patient : du laboratoire où est effectué le diagnostic à la pédiatrie puis en hématologie adulte avec une collaboration étroite entre infirmières de référence, psychologues, assistants sociaux et spécialistes d’organe.
La drépanocytose est une maladie génétique à transmission autosomique récessive, caractérisée par une anomalie de structure des chaînes de globines β constitutives de l’hémoglobine (hémoglobine anormale dite S). À l’état hétérozygote (porteur AS), elle ne donne pas, ou très peu, de manifestations cliniques. Par contre, chez les homozygotes porteurs de deux allèles mutés (notés SS) et les hétérozygotes dits composites associant un allèle S avec une autre hémoglobinopathie (hémoglobine C, hémoglobine E, β-thalassémie …), il en résulte des troubles cliniques graves variant d’une personne à l’autre. Les premiers signes ne se manifestent que 4-5 mois après la naissance, et les enfants malades présentent une anémie chronique et peuvent souffrir de crises hémolytiques, d’occlusions vasculaires et d’infections. Actuellement, on estime à 50 millions le nombre d’individus qui en sont atteints dans le monde, et à 300.000 le nombre annuel de naissances de formes majeures.
Particulièrement fréquente dans les populations d’origine africaine subsaharienne, des Antilles, d’Inde, du Moyen-Orient et du bassin méditerranéen, la drépanocytose a longtemps été considérée comme une maladie exotique. Toutefois, en raison des flux migratoires, elle est devenue un réel problème de santé publique dans les pays occidentaux, et tout particulièrement dans les centres urbains. En Belgique où la maladie ne fait pas partie du programme de dépistage néonatal obligatoire, une enquête épidémiologique récente a montré que la drépanocytose est la maladie génétique la plus fréquente avec des pics d’incidence en zones urbaines (Bruxelles, Anvers, Liège ...) comparables à ceux observés à Londres ou à Paris (1 cas de forme sévère pour 1.000 naissances et 20 porteurs de l’HbS pour 1.000 naissances au CHR de Liège).
Prise en charge
Le dépistage est essentiel, il permet de mettre en place :
- un suivi préventif, avec une recherche régulière des complications chroniques sévères;
- une éducation thérapeutique des patients et de leur famille;
- le traitement de première ligne (acide folique, prophylaxie anti-infectieuse, pénicilline chez l’enfant et vaccination renforcée);
- la proposition d’un conseil génétique (un dépistage prénatal ou pré-implantatoire peut aussi être proposé pour les grossesses ultérieures).
Ces mesures ont prouvé leur efficacité pour diminuer la morbidité et la mortalité des patients drépanocytaires. La prise en charge du patient drépanocytaire est assurée par une équipe multidisciplinaire, « le drépanogroupe », se composant de pédiatres spécialisés dans les hémoglobinopathies et d’hématologues adultes, d’un laboratoire performant dans les techniques de diagnostic des pathologies du globule rouge et dans les pratiques immuno-hématologiques et transfusionnelles, de radiologues réalisant des échographies Doppler transcrâniennes permettant de détecter les patients ayant un risque d’accident vasculaire cérébral, de l’équipe de greffe de moelle, de néphrologie et dialyse, d’anesthésistes/ réanimateurs, de chirurgiens, d’urgentistes, de gynécologues, de généticiens, de la clinique du voyageur, et de partenaires paramédicaux (assistants sociaux, diététiciennes, infirmières de coordination, infirmières impliquées et formées dans l’éducation thérapeutique, psychologues).
Cette multidisciplinarité et la collaboration avec les médecins traitants contribuent à un suivi optimal. La prise en charge aux urgences adultes et pédiatriques est très importante et a récemment fait l’objet d’un nouveau protocole standardisé dans notre institution. L’éducation thérapeutique se réalise à plusieurs niveaux :
- elle commence avec les parents, lorsque l’enfant est encore tout petit, mais celui-ci va rapidement être impliqué dans la gestion quotidienne de sa maladie;
- vers 5-6 ans, les premières explications peuvent être données aux enfants de manière imagée et plus l’enfant grandira, plus ces explications pourront être précises;
- à l’adolescence, le patient apprend à devenir acteur de sa prise en charge.
Pour faciliter cette éducation thérapeutique, l’équipe a créé plusieurs outils et organise régulièrement des événements : un carnet de suivi, des brochures et séances d’information autour de la drépanocytose, des ateliers explicatifs lors de la journée mondiale de la drépanocytose, des formations auprès des infirmières des centres PSE, des activités avec les adolescents ...
Intensification du traitement
Lorsque surviennent des complications (anémie sévère, anomalie de la vascularisation cérébrale, accidents ischémiques vaso-occlusifs, augmentation de la fréquence des crises vaso-occlusives), le traitement est intensifié par l’hydroxyurée ou la transfusion.
La transfusion sanguine est un élément majeur de la prise en charge du patient drépanocytaire. Les indications transfusionnelles sont bien codifiées pour éviter tout excès d’utilisation afin de réduire le risque immunologique post-transfusionnel de l’allo-immunisation érythrocytaire dont la forme la plus grave est l’hémolyse immédiate ou retardée. La transfusion doit être évitée tant que possible dans le traitement de la douleur. La prévalence de l’allo-immunisation est plus élevée chez le patient drépanocytaire polytransfusé que pour une autre pathologie et s’explique, au moins partiellement, par la disparité des antigènes de surface des hématies entre des donneurs majoritairement caucasiens et des receveurs d’origine africaine.
Afin de réduire ces risques, il conviendrait de :
- favoriser le recrutement de donneurs de sang d’origine africaine;
- avoir un suivi scrupuleux du dossier immuno-hématologique et transfusionnel du patient;
- utiliser au moins des concentrés de globules rouges phénotypes Rh/Kell compatibles;
- être attentif devant toute aggravation de la symptomatologie du patient drépanocytaire dans les suites d’une transfusion. Un chute du taux d’Hb en dessous du seuil pré-transfusionnel, mais surtout celui de l’HbA sont de bons marqueurs biologiques.
La question de l’abord veineux est très largement posée chez les patients drépanocytaires. Parmi les solutions proposées, existent la fistule artério-veineuse, ou certains types de PAC permettant la perfusion de sang à haut débit.
Le défi de la transition de la pédiatrie vers la médecine adulte
De nombreuses études démontrent que l’adolescence et le début de la vie adulte sont des périodes où les patients drépanocytaires connaissent un déséquilibre de leur pathologie avec parfois des hospitalisations plus fréquentes et l’apparition de complications aigües. Ce moment charnière de l’adolescence, entravée par la maladie chronique, coïncide souvent avec le délicat passage de la pédiatrie vers la médecine adulte (16-20 ans). Cette transition s’accompagne de craintes.
La compliance thérapeutique, essentielle dans la pathologie chronique, dépend en partie du lien de confiance entre le soignant et le soigné. Il faut que l’adolescent se sente acteur de sa santé et se prenne en charge. La collaboration entre les services de pédiatrie et de médecine adulte est essentielle, surtout dans ce moment délicat. Cette transition doit être planifiée individuellement, afin que le patient se sente attendu.
Dans cette optique, nous organisons, depuis 2013, un week-end autour de la transition pour les patients drépanocytaires. Il a pour but de permettre une rencontre entre des patients suivis en pédiatrie et d’autres suivis en médecine adulte, pour « démystifier » la transition. C’est aussi l’occasion de leur permettre de rencontrer les intervenants, de renforcer l’éducation thérapeutique et d’échanger leurs points de vue.
L’impact réel de ce week-end a été mesuré. Chez certains patients, on remarque une meilleure compliance thérapeutique et une relation médecin/patient renforcée.
Complications chroniques de la drépanocytose
- Insuffisance rénale;
- Atteintes hépatiques;
- Surcharge martiale liée aux transfusions, lithiases biliaires;
- Allo-immunisation;
- Complications ophtalmologiques;
- Lésions ostéo-articulaires;
- Lésions cardiaques;
- Lésions cérébrales;
- Lésions pulmonaires;
- Complications ORL;
- Ulcères cutanés;
- Répercussions psychologiques et sociales.
Perspectives
- Greffe de moelle osseuse. Il s’agit actuellement du seul traitement curatif de la drépanocytose. Les indications actuelles de greffe sont la vasculopathie cérébrale ou de nombreux crises vaso-occlusives et syndromes thoraciques aigus, persistant malgré une intensification de traitement. Seuls 10-20 % des patients ont un donneur compatible permettant cette option thérapeutique.
- Thérapie génique. Toujours à l’état de recherche, les premiers essais cliniques sont encourageants. Elle consiste à prélever les cellules souches du patient et y modifier le matériel génétique responsable de la production de l’hémoglobine. Ensuite, ces cellules sont réinfusées au patient, qui aura reçu un conditionnement myéloablatif.
- Nouvelles thérapeutiques. Beaucoup de nouvelles molécules sont actuellement à l’essai et leur efficacité est en cours d’évaluation. Notre centre participe activement au groupe de travail de la société belge d’hématologie BHS pour la prise en charge des maladies du globule rouge. Plusieurs études cliniques avec de nouvelles molécules pour diminuer la fréquence des crises douloureuses vont ainsi pouvoir démarrer tout prochainement au CHR de Liège, offrant de nouvelles options thérapeutiques aux patients.
17 ANS DE DÉPISTAGE NÉONATAL AU CHR LIÈGE
Le dépistage néonatal universel de la drépanocytose a été initié au CHR Liège en 2002. Il est financé, depuis cette date, par notre laboratoire. L’utilisation du sang de cordon permet d’assurer une prise en charge multidisciplinaire rapide avant la sortie du petit patient. Pour le dépistage primaire des hémoglobinopathies, il est nécessaire de réaliser les tests suivants : l’électrophorèse de l’Hb, l’hémogramme (indispensable à l’interprétation de l’électrophorèse de l’Hb), la ferritine (réserve en fer) et la CRP. L’interprétation de ces résultats nécessite une attention particulière. Il importe de ne pas se fier au seul hémogramme, celui-ci étant en effet le
plus souvent normal chez le porteur asymptomatique. Dans tous les cas de suspicion, parallèlement aux examens biologiques, une enquête familiale est souhaitable (s’il s’agit d’une femme enceinte, l’examen du père est recommandé).